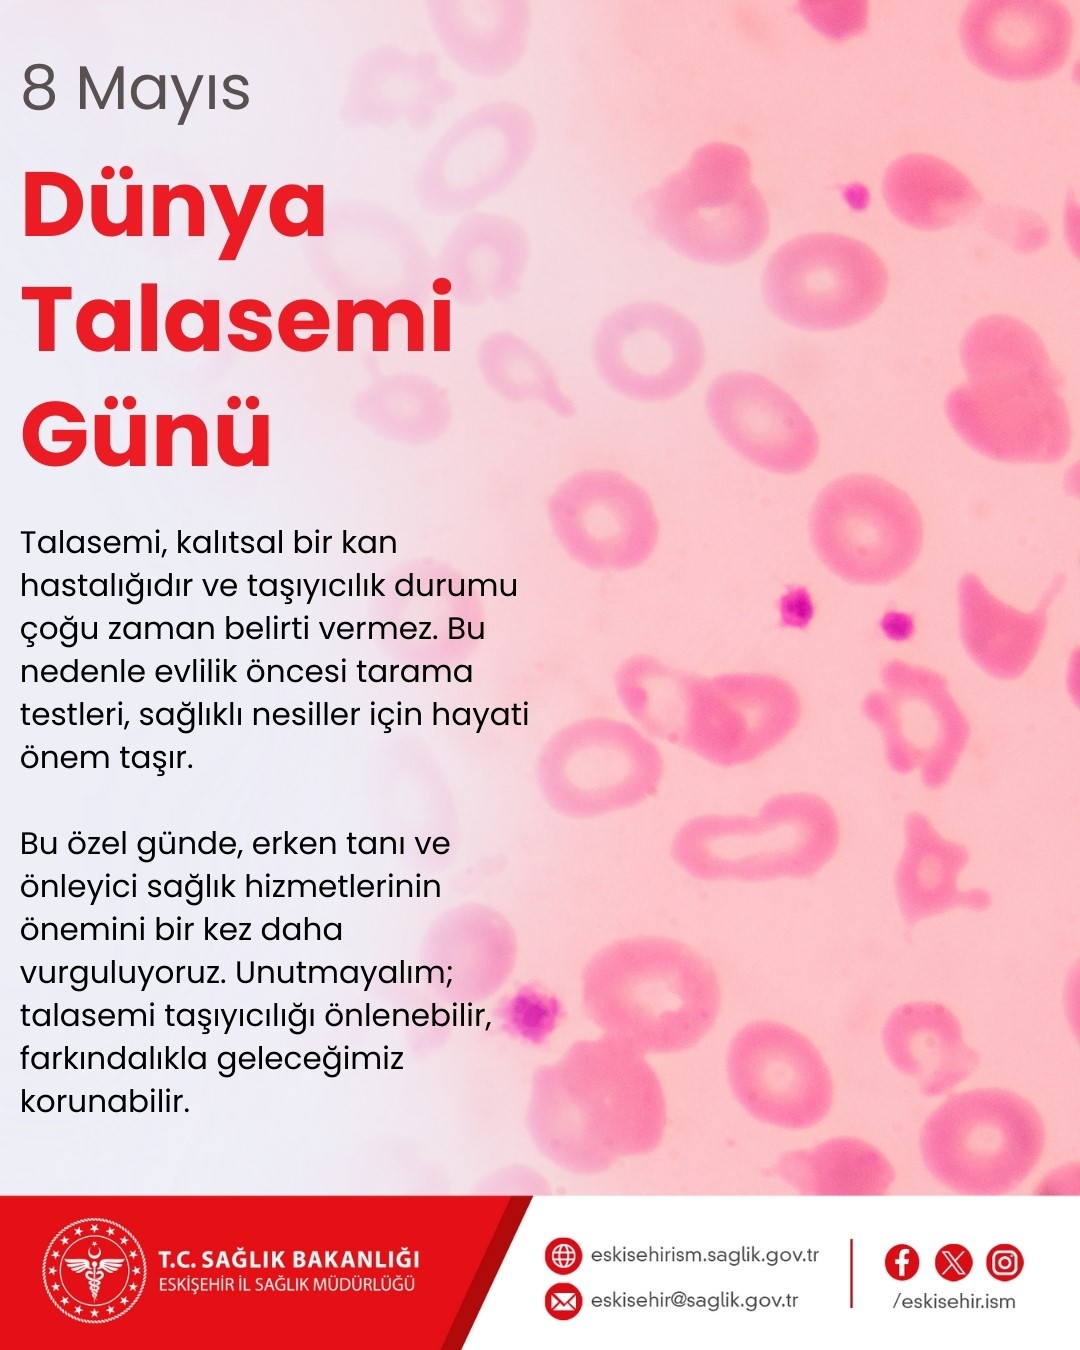
İl Sağlık Müdürü Bildirici ’Talasemi’ hakkında bilgilendirdi

Eskişehir İl Sağlık Müdürü Doç. Dr. Yaşar Bildirici 8 Mayıs Dünya Talasemi Günü dolayısıyla yayınladığı mesajında hastalık hakkında bilgilendirme yaptı.
Türkiye’de beta-talasemi taşıyıcılık oranının yüzde 2,1 olduğunu belirten Doç. Dr. Bildirici, bu oranın bölgelere göre yüzde 0,6 ile yüzde 13 arasında değiştiğini ifade etti. Akraba evliliklerinin sık olması nedeniyle genetik geçişli bir hastalık olan talasemi vakalarının arttığını kaydeden Bildirici, her yıl yüzlerce hasta çocuğun dünyaya geldiğini ve bunun aileler ile toplum üzerinde ciddi maddi ve manevi yükler oluşturduğunu dile getirdi. Talasemi taşıyıcılarının büyük bir kısmının hastalığı taşıdıklarının farkında olmadıklarına dikkat çeken Bildirici, "Genellikle ancak hasta bir çocuk dünyaya geldiğinde ya da özel kan testleri ile taşıyıcılık öğrenilmektedir" dedi.
"Bu tarama programı ile amaç, her iki eş adayının da taşıyıcı olması durumunda hasta bebek doğumunun önüne geçmek"
Türkiye’de 1 Kasım 2018 tarihinden itibaren "Evlilik Öncesi Hemoglobinopati Tarama Programı" adı altında uygulanan Hemoglobinopati Kontrol Programı uygulanıyor. Program kapsamında evlilik öncesi sağlık raporu almak isteyen çiftlere aile hekimleri aracılığıyla danışmanlık hizmeti verildiğini belirten Bildirici, erkek eş adayından alınan kan örnekleriyle tarama testlerinin yapıldığını; eğer erkek aday taşıyıcı çıkarsa kadın adayın da teste yönlendirildiğini söyledi. Bu tarama programı ile amaçlarının, her iki eş adayının da taşıyıcı olması durumunda hasta bebek doğumunun önüne geçmek olduğunu vurgulayan Bildirici, "Çiftlerden sadece birinin taşıyıcı olması evlenmelerine engel değildir. Ancak her iki eş adayının da taşıyıcı olması durumunda doğacak çocuklarda hastalık riski yüksek olmaktadır. Bu çiftler genetik danışmanlık merkezlerine yönlendirilmekte ve sağlıklı çocuk sahibi olmaları için gerekli bilgilendirmeler yapılmaktadır" şeklinde konuştu.
"Hasta bebek doğum riskinin önceden biliniyor olması büyük önem taşımaktadır"
Her iki eş adayının da taşıyıcı olduğu durumlarda, genetik danışmanlık alınarak tüp bebek uygulaması ve preimplantasyon genetik tanı yöntemleri sayesinde sağlıklı bebeklerin dünyaya gelebileceğini belirten Bildirici, "Hasta bebek doğum riskinin önceden biliniyor olması ve bir genetik tanı merkezinin takibinde olunması büyük önem taşımaktadır" dedi. Dünya genelinde 1993 yılından beri 8 Mayıs’ın "Dünya Talasemi Günü" olarak kutlandığını hatırlatan Doç. Dr. Bildirici, ülkemizde de çeşitli etkinliklerle hemoglobinopatilerin önemli bir halk sağlığı sorunu olarak gündemde tutulmasının ve toplumun bilinçlendirilmesinin hedeflendiğini sözlerine ekledi. Doç. Dr. Yaşar Bildirici açıklamasında, mevcut hemoglobinopati hastalarının yaşam süresinin uzatılması ve yaşam kalitelerinin artırılmasının da programın önemli hedeflerinden biri olduğunu vurgulayarak, "Talasemi önlenebilir bir hastalıktır. Bu konuda yapılan taramalar ve bilinçlendirme çalışmaları ile sağlıklı nesiller yetiştirmek mümkün olacaktır" dedi.